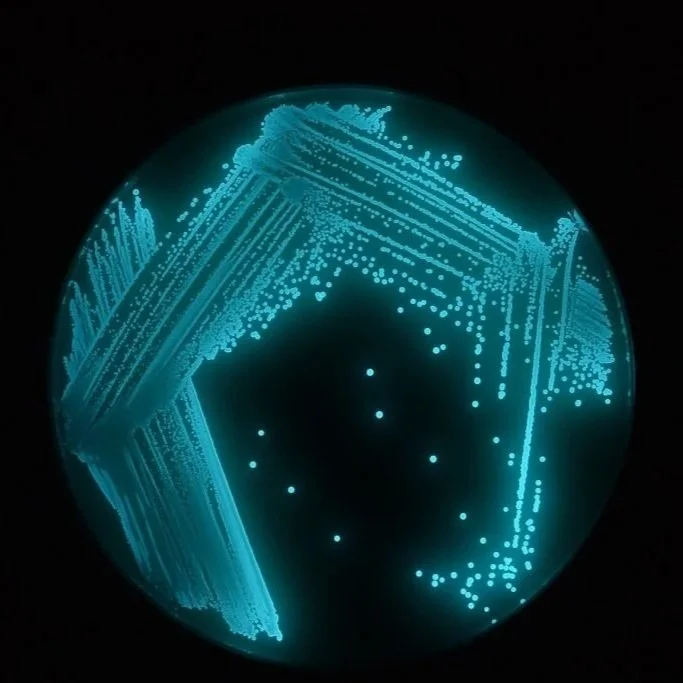
Aliivibrio_fischeri.jpg

05.01.26 - Biosensors Community Project Meeting
05.01.26 - Biosensors Community Project Meeting
Harnessing the POWER OF light for environmental monitoring!
Do you care about your environment and so happen to be a science enthusiast? If so, join us as we explore bioluminescent organisms as biosensors to detect heavy metals and other contaminants, with the ultimate goal of making science fun and accessible by creating a toolkit for our communities to conduct their own experiments. If synthesizing conclusions through gathering qualitative observations piques your interest, or if you’re fascinated by bioluminescent organisms, drop by SoundBio Lab on Friday, May 1st, 4:00 - 6:00 PM.
Free event. Ages 12 and up.
As a SoundBio Lab member, you can also participate outside of our public sessions. Learn more about membership HERE!
Funded in part by a Public Participation Grant from the Washington State Department of Ecology.